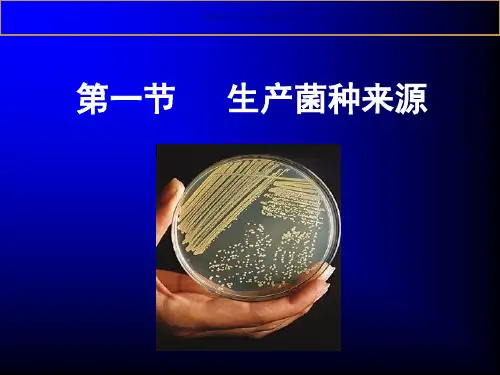

在分离培养中加入抗生素或某试剂可增加选择性(表2-4) 如: 分离真菌可在土豆培养基中加入链霉素;
分离细菌或放线菌可在培养基中加入制霉菌素等
资料仅供参考,不当之处,请联系改正。
选择性分离原理和技术
• 生长条件的选择与控制原理 –控制营养成分 –控制培养基酸碱度 –添加抑制剂 –控制培养温度 –控制通气条件
例如用此法分离产生碱性蛋白酶的芽孢杆菌
土壤经巴氏消毒,以减少不产芽孢的微生物;然后铺在 pH8-9的琼脂培养基(含有均匀的不溶性蛋白质)表面; 碱性蛋白酶产生菌能消化平板上的不溶性蛋白质,产生 一透明圈。
资料仅供参考,不当之处,请联系改正。
分离某种产生有机酸的菌株时,也通常采用透明 圈法初筛
• 常用于分离某些酶产生菌 • 选择压力:在选择培养基中加入所需酶
的基质
资料仅供参考,不当之处,请联系改正。
五、利用固体平板的生化反应进行分离
利用特殊的分离培养对大量混杂微生物进行初 步分离的方法。 分离培养基是根据目的微生物特殊的生理特性 或利用某些代谢产物生化反应来设计的。 可显著提高分离效率
• 选择性分离技术 –富集液体培养技术 –固体培养技术
资料仅供参考,不当之处,请联系改正。
A.富集液体培养
• 增加混合菌群中所需菌株数量的一种技术 • 技术特点:给混合菌群提供一些有利于目的菌株生长
或不利于目的菌以外的其他菌型生长的条件 • 培养方式
▪ 分批培养方式:以最大比生长速率 (μmax)筛选, 存在选择压力的控制、移种时间和次数等问题
某些必要试验和毒性试验
资料仅供参考,不当之处,请联系改正。
二、分离与筛选的设计要求
在筛选所需菌株时应考虑以下一些重要指标:
1、菌的营养特征 2、菌的生长温度